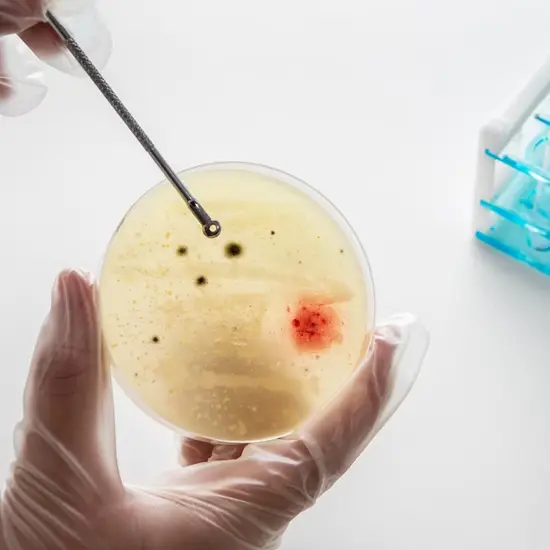

Book Urine Occult Blood Appointment Online Near me at the best price in Delhi/NCR from Ganesh Diagnostic. NABL & NABH Accredited Diagnostic centre and Pathology lab in Delhi offering a wide range of Radiology & Pathology tests. Get Free Ambulance & Free Home Sample collection. 24X7 Hour Open. Call Now at 011-47-444-444 to Book your Urine Occult Blood at 50% Discount.
The Occult blood is also known as as hematuria. IT is seen that generally frank bleeding is not common.
The incidence of hematuria majorly could be due to three causes such as systemic diseases are the following:
More than 5 RBCs per hpf is usually considered as abnormal.
While RBC casts are suggestive of the glomerulotubular source of hematuria.
Furthermore, the absence of the RBCs or the RBC casts despite a positive test result also suggests hemoglobinuria and/or myoglobinuria.
Note: The test usually requires a urine sample. If urine presents with red coloration, it would be observed under the microscope.
In case, the RBC is not observed, occult blood test (presence of hemologlobin in blood) will be performed.
It is seen that the positive results indicate any o f the following conditions:
|
0-3 RBC per hpf |
Males |
|
0-12 RBC per hpf |
Females |
Note : It might be possible that the blood in the urine is eliminated from the body with or without any pain.
Here are some guidelines an individual can refer to once they have decided to undergo a test to detect Urinary Tract Infection
The required documents needed for this test includes your valid government ID and an appropriate Doctor’s prescription.
Submit the sample to Ganesh Diagnostic Center or the technician would pick the sample form home for further testing.
No particular care is required, once the test sample has been collected.
At Ganesh Diagnostic and Imaging Centre, we are known for providing excellent service and care to its patients for decades. Lakhs of satisfied patients over the years!
It is an established and renowned diagnostic centre since 2001.
Their excellence is backed by NABH and NABL Accreditations.
NABH accreditation is proof of highest standard of care and service provided to the patients. NABL accreditation reflects the competency of laboratories and equipment based on some national and international standards.
Test report is available digitally too.
Ganesh Diagnostic and Imaging Centre is a one-stop solution for getting all kinds of tests done, as all services are available under one roof.
The aim of GDIC is to provide world’s finest technology at the lowest price.
The rates of scans are reasonably priced. Ganesh Diagnostic and Imaging Centre also offer FLAT 50% OFF on many tests.
Patients can rely upon test reports as reports are 100% accurate.
The approximate cost of this test is Rs 130-Rs160
| Test Type | Urine Occult Blood |
| Includes | Urine Occult Blood Test (Pathology Tests) |
| Preparation | Guidelines to follow before, during and after the testHere are some guidelines an individual can refer to once they have decided to undergo a test to detect Urinary Tract Infection The required documents needed for this test includes your valid government ID and an appropriate Doctor’s prescription. Before the Test
During the TestSubmit the sample to Ganesh Diagnostic Center or the technician would pick the sample form home for further testing. After the testNo particular care is required, once the test sample has been collected. |
| Reporting | Within 24 hours* |
| Test Price |
₹ 125
|

During the appointment, the healthcare professional takes a detailed medical history and also performs physical examinations that includes a pelvic exam or say a digital rectal exam (depending on occult blood in urine or in stool)
This can aid you and your healthcare professional to understand the symptoms way better.
Further tests ordered by the urologist to detect occult blood, include the following:
The following population is at risk of blood detection in their urine. This is as follows:
Treating the presence of blood in the urine typically depends on how strongly the actual cause of the hematuria is. Moreover, the provider would use any of the information that has been collected from the medical history or a physical exam and even the test results, so as to find the best treatment with patient centric approach.
The Bladder or the kidney stones have the potential to cause blood in the urine, which can also be seen with the naked eye itself.
It is seen that very severe or even prolonged dehydration can further lead to the presence of blood in the urine.
It has been established that not drinking sufficient water can further exacerbate any underlying kidney conditions which further contributes to hematuria, example- kidney stones.
An active bleeding within urinary tract has the potential to cause the blood clots in urine
Urine strip method
The Urine strips that are used in the hematuria screening check for occult blood.
The Reported values are as follows: (1+) (hemoglobin 0.06 mg/dL) or above value is considered to be positive.
As certain foods can vary the test results, a particular diet is often suggested for 48 to 72 hours before taking the test.
In addition, the patients should also avoid drugs such as-
At Ganesh Diagnostic and Imaging Centre, we are known for providing excellent service and care to its patients for decades. Lakhs of satisfied patients over the years!
It is an established and renowned diagnostic centre since 2001.
Their excellence is backed by NABH and NABL Accreditations.
NABH accreditation is proof of highest standard of care and service provided to the patients. NABL accreditation reflects the competency of laboratories and equipment based on some national and international standards.
Test report is available digitally too and received the very same day.
Note from Ganesh Diagnostic and Imaging Center
So, visit us at the earliest to ensure good health and to maintain an active immune system.
Early check ups are always better than delayed ones. Safety, precaution & care is depicted from the several health checkups. Here, we present simple & comprehensive health packages for any kind of testing to ensure the early prescribed treatment to safeguard your health.